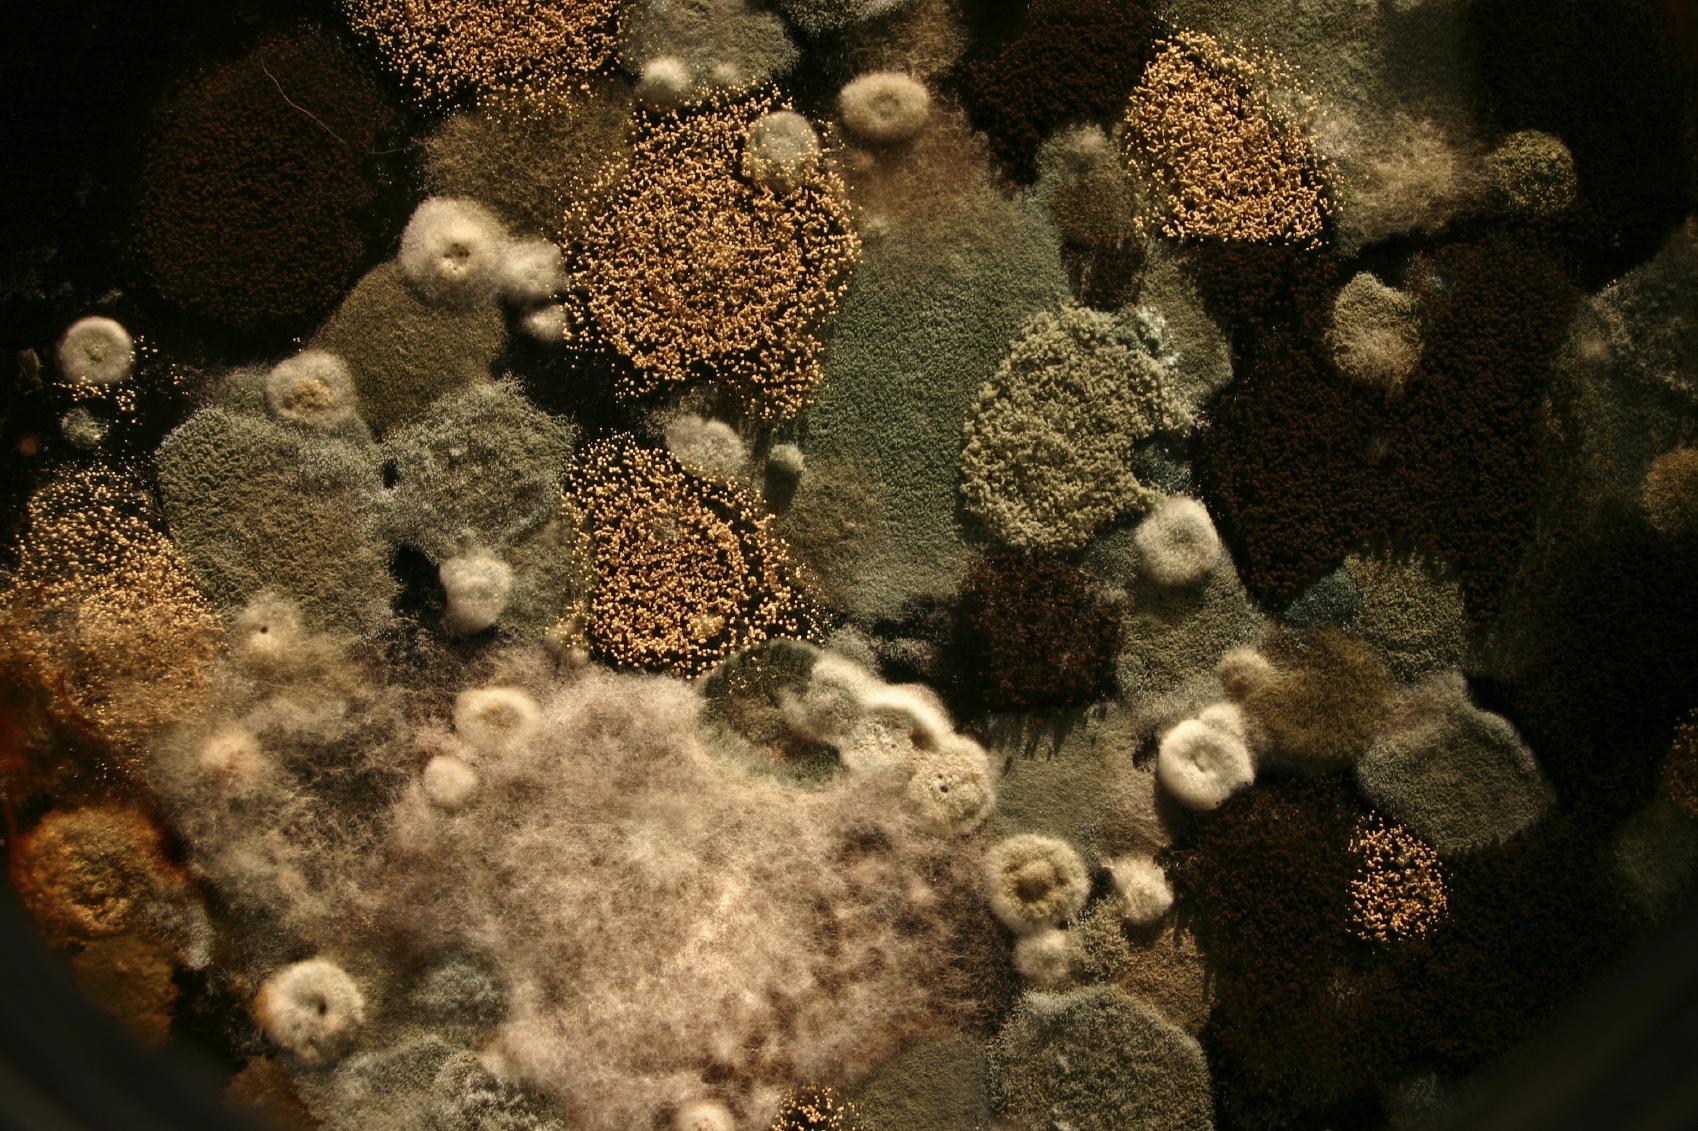

a.janousek | Středa, 15. leden 2014 |
Tento článek je posledním z našeho pětidílného seriálu Domácí plísně. Z předchozích dílů víte o plísních mnoho - dnešní se však věnuje tomu nejdůležitějšímu - vlivu plísní a jejich produktů na lidské zdraví.
Ošklivý povlak plísně na stěně či vybavení a ani nepříjemný zápach většinu lidí nevede k rychlému řešení - odstranění dle vzhledu neškodného nepřítele..
Alergie i astma
Již před více jak dvěma stoletími byl za původce dýchacích obtíží ženců obilí usvědčen obilný prach, který obsahuje plísně a jejich produkty. Lidé obývající zaplísněné domácnosti si neuvědomují, že plíseň je velmi zákeřným spolubydlícím.
Jak již bylo psáno v předchozím dílu, plíseň "dostává zelenou" ve stavbě, kde se hromadí vzdušná vlhkost a stavba je po technické stránce v nepořádku. Plíseň roste pomalu, ale jistě. Plocha v řádech decimetrů čtverečních nevyroste tzv. ze dne na den - proto při objevení prvních barevných skvrn je nutné začít jednat s chemií v ruce. Je-li obyvatel laxní, plíseň se díky sporům dokáže rozšířit po celé bytové jednotce. Toxické spory a úlomky těl plísní poletují vzduchem a obyvatel je nevědomky vdechuje...
Inhalace vede v počátcích u vnímavějších jedinců k bolestem hlavy, únavě, pálení očí, kůže a sliznic dýchacího traktu. Později může dojít i k odstartování astmatu a alergií na některé druhy plísní - často se přidružují i jiné alergie.
velikosti vdechovaných spor se odvíjí závažnost onemocnění - čím menší spory, tím závažnější jsou onemocnění. Větší spory než 10 µm způsobují "pouze" podráždění sliznic horních cest dýchacích. Spory od 4 do 10 µm vnikají hlouběji - do průdušek a průdušnice, kde mohou vyvolat astma. Spory menší než 4 µm vnikají nejhlouběji - do plicních sklípků, kde mohou vyvolávat zánětlivá onemocnění. Do plicních sklípků jsou schopna se dostat i vlákna azbestu (článek ZDE), která dosahují i velikosti 0,5 µm.
Z cihly do dřeva
Dříve stavěné domy neměly vážnější problémy s plísněmi do doby, než klasická kamna nahradilo ústřední vytápění a instalovala se velmi těsná okna, která majitelé prakticky neotevírají. Je to logický vývoj - s energií se musí šetřit, ale ne na úkor zdraví. Zděné stavby se po těchto "vylepšeních" stávají nebezpečnými pro své obyvatele - v mnoha případech jsou markantně zaplísněny. Velké množství osvícených lidí se rozhodlo neinvestovat do rekonstrukce staré stavby (s často dysfunkční hydroizolací základů) a raději starý dům opustili či zbourali a na jeho místě postavili dům nový. Po nepříjemných zkušenostech se tito osvícení raději straní zděných staveb a inklinují k dřevostavbám, kde se plíseň nemá šanci vyskytovat díky silné vrstvě tepelné izolace a vzduchotechnice.
Zdroj informací: "Plísně v domě a bytě" - Kateřina Klánová
Grada Publishing
Další díly seriálu o plísních:
Domácí plísně 1: Kdo jsou a proč se ve stavbě vyskytují
Domácí plísně 2: Životní potřeby
Domácí plísně 3: Má je každý
Domácí plísně 4: Topit a větrat!
Domácí plísně 5: Zdravotní obtíže (tento článek)
Nejnovější články v kategorii “Zdravé bydlení”
-
Vliv centrálního vysavače na kvalitu života
Centrální vysavač nevíří prach, to je prostě fakt, který nelze zpochybnit. Veškerý nasátý vzduch včetně nečistot, alergenů a roztočů odvádí trubním rozvodem mimo obytné…
-
Jak vyzrát na alergeny v domácnosti
Jsou malí, nenápadní, ale dokážou pořádně znepříjemnit život. O co se jedná? Alergeny. Obzvláště s příchodem jara a období všudypřítomného pylu číhají prakticky na každém…
-
Zdravé prostředí bez alergenů pomůže v domě zajistit centrální vysavač
V souvislosti s množícími se alergiemi a viry je třeba zajistit co nejzdravější vnitřní prostředí v domě. Velmi účinným prostředkem, který můžete do boje za čistý domov nasadit,…
-
I u nás to jde! Ze dřeva se staví (nejen) školy a školky
Podle statistik z posledních let se v Česku každoročně postaví bezmála tři tisíce dřevostaveb. Jedná se především o rodinné domy, ale postupně přibývají i další typy staveb s…

Vytvořeno v xart.cz